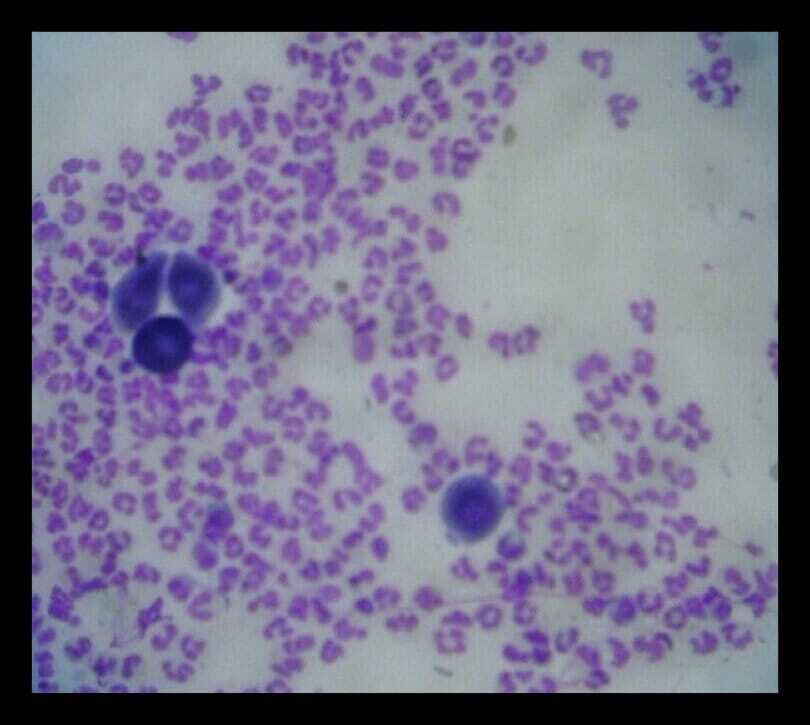
impression smear from ruptured pustule in canine pemphigus

Bei Hauterkrankungen sind eine ausführliche Anamnese, eine vollständige klinische Untersuchung zur Feststellung des Gesundheitszustands des Patienten und eine dermatologische Untersuchung sinnvoll. Auf dieser Grundlage kann eine Liste mit Differenzialdiagnosen erstellt werden. Ordnet man diese nach ihrer Wahrscheinlichkeit, zeigt sich, welche diagnostischen Tests zur Sicherung der Diagnose sinnvoll sind. Die Rangfolge ist wichtig, da sie eine gezielte Durchführung der Tests ermöglicht und unnötige Kosten vermeidet.
Geschulte TFA spielen eine wichtige Rolle in der dermatologischen Betreuung.
Bereits bei der Erstkonsultation können sie helfen, eine vertrauensvolle Beziehung zu den Besitzer*innen aufzubauen und im weiteren Verlauf als feste Ansprechperson für Rückfragen zur Verfügung zu stehen.
Zudem können sie in vielen Fällen die erforderlichen In-House-Schnelltests übernehmen, einschließlich der sechs in diesem Artikel beschriebenen Untersuchungsverfahren.
Die erforderliche Ausrüstung für die sechs hier beschriebenen Tests ist minimal. Sie besteht aus Diff-Quik-Färbemitteln, Objektträgern/Deckgläsern, einem Mikroskop mit niedriger, mittlerer und hoher Vergröβerung (einschließlich Ölimmersion) und einer hochwertigen Wood-Lampe.
Bürsten des Fells

Dieser sehr einfache Test, der in der Praxis vielleicht zu wenig genutzt wird, ist ein nützliches Mittel zum Nachweis von Ektoparasiten, Eiern, Flohkot und Follikelanomalien.
Das Tier sollte über dem zuvor gereinigten Behandlungstisch gebürstet werden. Die Haare und Epithelreste sollten gesammelt und die Haare von den Schuppen getrennt werden. Die Haare werden in eine Petrischale gelegt, damit sie mit der Wood'schen Lampe untersucht werden können. Für die mikroskopische Untersuchung sollten sie in flüssiges Paraffinöl mit einem Deckglas eingebettet werden. Die Schuppen werden ebenfalls in flüssiges Paraffin eingebettet und mit einem Deckglas versehen.
Es können Läuse, Nissen, Cheyletiellen und fragmentierter Flohkot gefunden werden, der bei einer Flohbissallergie makroskopisch übersehen werden kann (Abbildung 1).
Mikroskopische Untersuchung von ausgezupften Haaren und Haarwurzeln (Trichoskopie)
Das Auszupfen von Haaren ist ein kostengünstiger und schneller Test auf Demodikose, insbesondere in Bereichen, in denen das Ausschaben der Haut schwierig ist, wie beispielsweise den Pfoten. Die Haare werden aus den erkrankten Bereichen entnommen, die bei der dermatologischen Untersuchung aufgefallen sind. Die Haare werden mit einer Pinzette aus der Peripherie der Läsion ausgezupft, in flüssiges Paraffinöl gelegt und mit einem Deckglas versehen.




Bei schwacher Vergrößerung (x40) werden Demodex-Milben (Abbildung 2) oft in Verbindung mit den Haarschäften gefunden, so dass in dem Falle keine invasiveren Hautausschabungen erforderlich sind. Cheyletiellen Milben können ebenfalls durch Auszupfen der Haare diagnostiziert werden. Entweder die Milbe selbst oder, was häufiger der Fall ist, die von feinen Fäden am Haarschaft umschlossenen Eier (Abbildung 3). Weiterhin können sowohl Dermatophytosen nachgewiesen werden (Abbildung 4), als auch juckreizbedingte Haarschäden und Hyperkeratosen (Abbildung 5).
Auskratzen der Haut
Das tiefe Ausschaben der Haut ist etwas zeitaufwendiger als die vorangegangenen Tests, ist aber bei Verdacht auf Parasitenbefall unerlässlich, wenn weniger invasive Tests negativ ausfallen. Es dient in erster Linie dem Nachweis von Haarbalgmilben (Demodex) und Grabmilben (Sarcoptes). Zum Nachweis von Cheyletiellen ist ein eher oberflächliches Hautgeschabsel erforderlich.
Bei Demodikose ist ein tiefes Hautgeschabsel erforderlich. Entfernen Sie gegebenenfalls die Haare mit einer Schere. Drücken Sie die Haut an der Peripherie der Läsion, zusammen und tragen Sie einen Tropfen flüssiges Paraffinöl auf. Dadurch wird die Aufnahme des Materials erleichtert.
Verwenden Sie eine stumpfe Skalpellklinge und schaben Sie mehrfach flach in Richtung des Haarwuchses. Es wird so lange mit moderatem Druck geschabt, bis eine leichte kapilläre Blutung auftritt. Die Gewebeprobe wird von der Skalpellklinge auf einen Objektträger übertragen, mit flüssigem Paraffin vermischt, und mit einem Deckglas versehen. Die Untersuchung wird mit starkem Kontrast durchgeführt (Kondensorblende schliessen).
Bei Krätze (Sarcoptes) sind mehrere oberflächliche und tiefe Abstriche von geröteten, verkrusteten Bereichen erforderlich. Dies liegt daran, dass viele Fälle mit einer Überempfindlichkeit gegen Sarcoptes scabiei einhergehen und der Nachweis aufgrund der geringen Anzahl von Milben oft schwierig ist. Das Scannen des Objektträgers (zunächst unter niedriger Vergrößerung) erleichtert die Identifizierung der Milben. Flüssiges Paraffin tötet die Milben nicht ab, und subtile Bewegungen können helfen, diese zu sehen.
Klebebandstreifen
Ein Klebestreifenpräparat (Tesa-Abklatsch) ist ein äußerst nützlicher und vielseitiger diagnostischer Test. Er ist schnell, kostengünstig und liefert oft wertvolle diagnostische Informationen. Es ist eine Technik, die routinemäßig von Veterinärdermatologen angewandt wird, da sie zur Diagnose von oberflächlichen Pyodermien (Abbildung 6), bakteriellen Sekundärinfektionen, einigen Autoimmunkrankheiten und Parasiten eingesetzt werden kann. Ein Klebestreifenpräparat ist die gängigste Methode zur Diagnose von Malassezia-Dermatitis oder -Überwucherung (Abbildung 9).
Mehrere 10 cm lange Klebebandstücke werden auf die Hautoberfläche gedrückt.
Die Probe wird zunächst bei geringer Vergrößerung auf Parasiten wie Demodex, Sarcoptes, Cheyletiellen und Läuse untersucht. Zur Identifizierung von Bakterien oder Malassezia wird das Klebeband teilweise auf dem Objektträger befestigt und mit Diff-Quik angefärbt. Danach erfolgt die mikroskopische Untersuchung bei höherer Vergrößerung, gegebenenfalls unter Verwendung von Ölimmersion.

Einige Marken von Klebebändern lösen sich mit dem Fixiermittel auf; in diesen Fällen kann auf die Fixierung verzichtet werden. Ultra-transparente Klebebänder können ohne Verlust des Bandes fixiert werden und liefern im Allgemeinen bessere Ergebnisse.
Objektträgerabdrücke und Tupferabstriche
Bei eitrigen oder exsudativen Läsionen sollten Objektträgerabdrücke von der Oberfläche der Läsion genommen werden. Diese Technik ist wertvoll für die Unterscheidung zwischen bakteriellen Infektionen und sterilen Läsionen, wie sie bei Pemphigus foliaceus auftreten (Abbildungen 7 und 8).
Geeignete Bereiche für die mikroskopische Untersuchung des Präparates werden unter schwacher Lichtstärke zunächst lokalisiert; die Identifizierung von Bakterien und Malassezia (Abbildung 9) wird dann unter hoher Lichtstärke mit Ölimmersion durchgeführt. Der Objektträger wird gegen die feuchte Läsion gedrückt, fixiert und mit Diff-Quik angefärbt. Alternativ kann bei eitrigem Material, einschließlich gestochener Pusteln, ein Tupfer verwendet werden, um das Material aufzunehmen. Der Tupfer wird dann vorsichtig auf dem Objektträger abgerollt.
Untersuchung mit der Wood'schen Lampe
Die Untersuchung mittels Wood’scher Lampe ist ein sehr nützlicher und kostengünstiger Screening-Test für Microsporum canis bedingte Dermatophytose (andere Dermatophyten von veterinärmedizinischer Bedeutung fluoreszieren nicht). Es ist wichtig, dass die Wood’sche-Lampe von einem anerkannten Veterinärlieferanten stammt. Wood’sche Lampen erzeugen ultraviolettes Licht. Qualitativ hochwertige Wood'sche-Lampen haben zwei Farbindikationen und eine eingebaute Vergrößerungslinse.
Die Untersuchung muss in einem sehr dunklen Raum stattfinden. Wärmen Sie die Lampe etwa fünf Minuten lang auf. Scannen Sie das Tier ein paar Minuten lang, da die Fluoreszenz manchmal verzögert auftritt. Positionieren Sie die Lampe auch über den durch Bürsten gesammelten Haaren, da viele Dermatophytose-Haare beschädigt sind und daher leicht durch Bürsten entfernt werden können.

ABBILDUNG 10 Fluoreszierende Haare einer Katze mit Dermatophytose verursacht durch Microsporum canis. Die infizierten Haarschäfte leuchten apfelgrün. Die Hintergrundfluoreszenz ist negativ (nicht infizierte Haare: blau)
Nur grüne Fluoreszenz entlang von Haarschäften gilt als positiv, denn Schuppen, Krusten und gewisse topische Präparate können ebenfalls aufleuchten (Abbildung 10).
Positiv fluoreszierende Haare können ausgezupft, mikroskopisch untersucht und zur Bestätigung kultiviert werden. Es ist auch sinnvoll, allen anwesenden Tierärzt*innen und TFA die positive Fluoreszenz zu demonstrieren, da die Fluoreszenz auffällig und lehrreich ist.
Die oft zitierte Zahl, dass nur 50 Prozent der M. canis-Haare fluoreszieren, ist falsch. Bei korrekter Anwendung kann eine deutlich höhere Erkennungsrate erzielt werden. Allerdings schließt eine negative Fluoreszenz eine Infektion nicht aus.
Wir danken Ross Bond, Anette Loeffler und den Kolleg*innen vom dermatologischen Dienst des Royal Veterinary College für die Verwendung der Abbildungen.
Autor*in
David Grant, MBE, BVetMed, CertSAD, FRCVS, graduated from the RVC in 1968 and received his FRCVS in 1978. David recently retired as hospital director at RSPCA Harmsworth after 25 years. He was a RCVS Specialist in Veterinary Dermatology (now retired) and president of the European Society of Veterinary Dermatology. David and now writes and lectures internationally.

